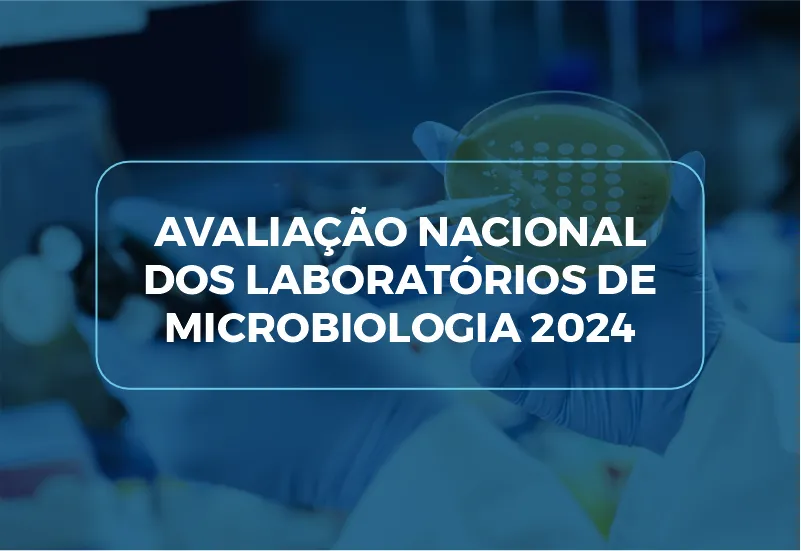
AVALIAÇÃO NACIONAL DOS LABORATÓRIOS DE MICROBIOLOGIA 2024

Notícias
Últimos Posts
Eficácia de duo teste brasileiro para diagnóstico de síflis e HIV é reconhecida internacionalmente
A tecnologia do duo test, solução digital mais moderna que os atuais testes rápidos disponíveis no mercado, vem sendo desenvolvida desde 2018 pelos pesquisadores brasileiros e, mais recentemente, foi chancelada por meio de um artigo.Um ...
» Leia MaisAVALIAÇÃO NACIONAL DOS LABORATÓRIOS DE MICROBIOLOGIA 2024
O PNCQ, em parceria com a SBAC, divulga a Avaliação Nacional dos Laboratórios de Microbiologia 2024, realizada pela Agência Nacional de Vigilância Sanitária (ANVISA), em parceria com a Coordenação-Geral de Laboratórios de Saúde ...
» Leia MaisSEMANA MUNDIAL DO PROFISSIONAL DO LABORATORIO CLÍNICO
SEBIOCLI NACIONAL e SEBIOCLI PICHINCHA convidam você para a celebração da Semana Mundial do Profissional de Laboratório Clínico (Global MedLab Week 2024) e a assistir ao Webinar ao vivo com os temas: • Epidemiologia e Controle de ...
» Leia MaisPodcast: Revisión del estado del arte de Chagas en Latinoamérica – Amadeo Saez
A Radio el Microscopio (Infobioquímica) disponibiliza a entrevista sobre Chagas do Dr. Amadeo Sáez-Alquezar, Farmacêutico-Bioquímico, Mestre em Análises Clínicas e Toxicológicas pela USP, Assessor Científico do PNCQ em Sorologia p...
» Leia MaisTriagem de doenças infecciosas em banco de sangue: exames, estratégias e controle de qualidade
O Assessor Científico do PNCQ em Sorologia para Bancos de Sangue – Dr. Amadeo Sáez-Alquezar – apresentou o tema “Tamizaje para enfermedades infecciosas en banco de sangre: Pruebas, estrategias y control de calidad” (Triagem de doe...
» Leia MaisDiseño de estudios sobre pruebas médicas
O Curso de formación básica en investigación clínica y epidemiológica (2023-2024) do GCIAMT (Grupo cooperativo iberoamericano de medicina transfusional) é coordenado pela Dra. Mirta Remesar. No módulo 12, contou com a apresentaç...
» Leia MaisPNCQ LANÇA O SOFTWARE PNCQ GESTOR VERSÃO 8.0
Está disponível o software PNCQ Gestor Versão 8.0, em atendimento aos requisitos do Manual do SNA-DICQ 8ª ed. e da RDC 786:2023 da ANVISA. O PNCQ incentiva seus Associados a implantarem um Sistema de Gestão da Qualidade (SGQ) visand...
» Leia MaisCTEL – Codificação e Terminologia nos Exames de Laboratório
A CTEL – Codificação e Terminologia nos Exames de Laboratório conta com o apoio e o patrocínio do PNCQ – Programa Nacional de Controle de Qualidade e da SBAC – Sociedade Brasileira de Análises Clínicas, para viabilizar as suas a...
» Leia MaisA importância de trabalhar o calendário da saúde no seu laboratório
As campanhas mensais de saúde são um alerta para a conscientização, debates sobre cada doença, prevenção e troca de experiências com pessoas que superaram estas enfermidades. A importância de todas essas campanhas se reflete na dis...
» Leia MaisSELO DE QUALIDADE
O Selo de Qualidade é disponibilizado pelo PNCQ pra que os laboratórios possam divulgar, aos seus clientes, a sua participação no Programa Nacional de Controle de Qualidade. Tem direito ao recebimento dos Selos de Qualidade, os Laborat�...
» Leia MaisBusca
Últimos Posts
Categorias

Inscreva-se para receber Informativos
Nosso objetivo é facilitar a obtenção de informações a respeito do funcionamento do PNCQ e sobre Controle de Qualidade e Gestão da Qualidade no labotatório, assine e fique informado(a).